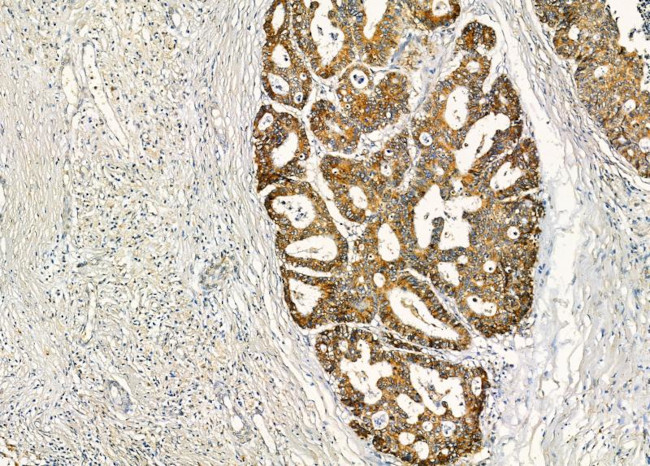
LILRB2 Antibody in Immunohistochemistry (Paraffin) (IHC (P))

Search
Invitrogen
LILRB2 Polyclonal Antibody
{{$productOrderCtrl.translations['antibody.pdp.commerceCard.promotion.promotions']}}
{{$productOrderCtrl.translations['antibody.pdp.commerceCard.promotion.viewpromo']}}
{{$productOrderCtrl.translations['antibody.pdp.commerceCard.promotion.promocode']}}: {{promo.promoCode}} {{promo.promoTitle}} {{promo.promoDescription}}. {{$productOrderCtrl.translations['antibody.pdp.commerceCard.promotion.learnmore']}}
图: 1 / 2
LILRB2 Antibody (PA5-103913) in IHC (P)


Please note: We are reviewing Western blot images included in the antibody testing data in our catalog, including those provided by third parties. Unless expressly labeled or annotated as “raw-unedited”, Western blot images included in the antibody testing data in our catalog may have been edited, optimized or otherwise adjusted for presentation.
产品信息
PA5-103913
种属反应
宿主/亚型
分类
类型
抗原
偶联物
形式
浓度
规格
纯化类型
保存液
内含物
保存条件
运输条件
RRID
产品详细信息
Antibody detects endogenous levels of total LILRB2.
靶标信息
CD85d, also known as LILRB2 or ILT4, is a member of the immunoglobulin-like transcript (ILT), leukocyte Ig-like receptor (LIR), and monocyte Ig-like receptor (MIR) family. It is a 110 kDa single transmembrane receptor with three Ig-like domains and a long cytoplasmic domain containing immunoreceptor tyrosine-based inhibitory motifs (ITIMs). CD85d is expressed on monocytes, macrophages, and dendritic cells. The receptor binds to non-classical class I molecules such as HLA-G, -B, and G1. Upon ligand binding, the tyrosine phosphatase SHP-1 interacts with the ITIMs, transducing a negative signal that inhibits immune response stimulation. This interaction is thought to contribute to tolerance during fetal implantation and plays a role in controlling inflammatory responses and cytotoxicity, helping to focus the immune response and limit autoreactivity. CD85d is also involved in organ allograft rejection, with the levels of ILT3 and ILT4 on dendritic cells suggesting its role in this process. The LILRB2 gene, located in a gene cluster at chromosomal region 19q13.4, encodes multiple transcript variants with different isoforms, highlighting its complexity and importance in immune regulation.
仅用于科研。不用于诊断过程。未经明确授权不得转售。
篇参考文献 (0)
生物信息学
蛋白别名: CD85 antigen-like family member D; CD85d; CD85d antigen; ILT-4; Immunoglobulin-like transcript 4; Leukocyte immunoglobulin-like receptor subfamily B member 2; LIR-2; LIR2CD85D; MIR-10; MIR10LILRA6; Monocyte/macrophage immunoglobulin-like receptor 10
基因别名: ILT4; LILRB2; LIR2; MIR10
Entrez Gene ID: (Human) 10288